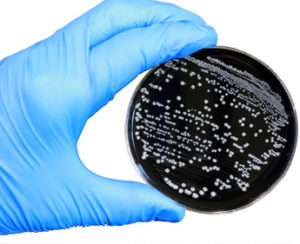

Kerntemperaturen richtig erhitzen – ein oft unterschätztes Risiko in der Gastronomie
Checking meat temperature while grilling Die unzureichende Erhitzung von Speisen gehört aktuell zu den häufig vernachlässigten Punkten bei Kontrollen in Gastronomie und Gemeinschaftsverpflegung. Besonders kritisch ist dabei Geflügel, da es ein hohes Risiko für pathogene Keime wie Salmonella und Campylobacter aufweist. Gesetzliche und fachliche Anforderungen (CH & DE) Sowohl in der Schweiz (HyV, Hygieneverordnung) als auch in Deutschland (LMHV, EU (VO) 852/2004) gilt klar:…